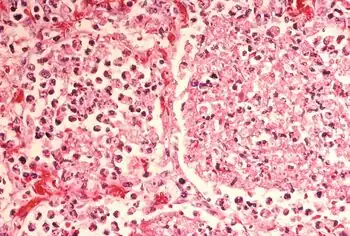

List of Legionnaires' disease outbreaks
This is a list of Legionnaires' disease outbreaks; Legionnaire's is a potentially fatal infectious disease caused by gram negative, aerobic bacteria belonging to the genus Legionella.[1][2] The first reported outbreak was in Philadelphia, Pennsylvania in 1976 during a Legionnaires Convention at the Bellevue-Stratford Hotel.[3]
An outbreak is defined as two or more cases where the onset of illness is closely linked in time (weeks rather than months) and in space, where there is suspicion of, or evidence of, a common source of infection, with or without microbiological support (i.e. common spatial location of cases from travel history).[4]
Worldwide listings by year
1960s
| Year | City | Venue | Source | Cases | Deaths | Fatality rate | Notes |
|---|---|---|---|---|---|---|---|
| 1965 | Washington, D.C., United States | St. Elizabeths Hospital | Unknown | 94 | 16 | 17% | The outbreak occurred in 1965, but was not identified as legionnaires' disease until saved blood serum was exposed to bacterial samples from the 1976 Philadelphia Legionnaires' disease outbreak.[5] |
1970s
| Year | City | Venue | Source | Cases | Deaths | Fatality rate | Notes |
|---|---|---|---|---|---|---|---|
| 1973,1977 | Benidorm, Spain | Hotel Rio Park | Shower pipes | at least 4 | 4 | unknown | The first outbreak in Hotel Rio Park occurred in 1973, four tourists died, but at the time it was not recognized as Legionnaires' disease until a subsequent outbreak in the same hotel in 1977.[6] |
| 1976 | Philadelphia, Pennsylvania, United States | 1976 Philadelphia Legionnaires' disease outbreak | Air conditioning | 221 | 34 | 15.4% | This was the first recognized outbreak of legionellosis, although earlier cases of legionellosis were later discovered to have occurred as far back as 1947. The Philadelphia outbreak, however, had the highest death rate.[7][8][9] |
| 1978 | Memphis, Tennessee, United States | Baptist Memorial Hospital-Memphis (1912–2000) | air-conditioning cooling tower | 44 | 1978 Memphis Legionnaire's Disease Outbreak Archived 2022-12-08 at the Wayback Machine | ||
| 1979 | Melbourne, Australia | light industrial building | medium-sized evaporative condenser | [10] | |||
| 1979 | Ballarat, Australia | psychiatric hospital | shower water system | [10] | |||
1980s
| Year | City | Venue | Source | Cases | Deaths | Fatality rate | Notes |
|---|---|---|---|---|---|---|---|
| 1985 | Wollongong, Australia | social club building | small cooling tower | [10] | |||
| 1985 | Stafford, England | Stafford District Hospital | Air conditioning | 175 | 28 | 16% | In April 1985, 175 patients were admitted to the District or Kingsmead Stafford Hospitals with chest infection or pneumonia. A total of 28 people died. Medical diagnosis showed that Legionnaires' disease was responsible and the immediate epidemiological investigation traced the source of the infection to the air-conditioning cooling tower on the roof of Stafford District Hospital. |
| 1986 | Adelaide, Australia | community | small cooling tower at hospital | [10] | |||
| 1987 | Wollongong, Australia | shopping centre | small cooling tower at a shop | [10] | |||
| 1988 | Adelaide, Australia | community | potting mixes | [10] | |||
| 1989 | Sydney, Australia | bowling club | small cooling tower | [10] | |||
| 1989 | Burnie, Australia | community | small cooling tower at hospital | [10] | |||
1990s
| Year | City | Venue | Source | Cases | Deaths | Fatality rate | Notes |
|---|---|---|---|---|---|---|---|
| 1992 | Sydney, Australia | shopping centre | small cooling tower | [10] | |||
| 1994 | Sunshine Coast, Australia | holiday apartment unit | private spa pool | [10] | |||
| 1995 | Sydney, Australia | shopping centre | small cooling tower at hospital | [10] | |||
| 1999 | Bovenkarspel, Netherlands | 1999 Bovenkarspel legionellosis outbreak | Hot tub | 318 | 32 | 10% | In March 1999, an outbreak in the Netherlands occurred during the Westfriese Flora flower exhibition in Bovenkarspel. 318 people became ill and at least 32 people died. There is a possibility that more people died from it (which might make it the deadliest recorded outbreak), but these people were interred before the Legionella infection was recognized. The source of the bacteria was a hot tub in the exhibition area.[11][12] |
2000s
| Year | City | Venue | Source | Cases | Deaths | Fatality rate | Notes |
|---|---|---|---|---|---|---|---|
| 2000 | Melbourne, Australia | Sea Life Melbourne Aquarium | Cooling tower | 125 | 4 | 3.2% | In April 2000, an outbreak of Legionella pnemophila serogroup 1 occurred in Melbourne, Australia. The outbreak resulted in 125 confirmed cases of Legionnaire's disease, with 95 (76%) hospitalised. It is reported that 4 died from the outbreak. The investigation traced the source of the infection to the cooling tower at the newly opened aquarium.[13] Since this outbreak, legionella infection statistics are required to be reported by the state government as a notifiable disease.[14] Regulations were introduced by the state to control legionella in 2001.[15] |
| 2000 | Vizela, Portugal | Public square | Decorative fountain | 11 | 0 | 0% | In August 2000, an outbreak of Legionnaires' disease occurred in Vizela, Northern Portugal.[16] A total of 11 persons with Legionnaires' disease were admitted to the hospital.[17] There were no fatalities. All patients had been in the main square of Vizela in the night of August 11–12, 2000, where the annual festivities of the municipality were being held.[16] Investigators traced the source of the outbreak to a decorative fountain located in the square.[17] |
| 2001 | Murcia, Spain | Hospital | Cooling Towers[18] | 800+ | 6 | 0.8% | The world's largest outbreak of Legionnaires' disease happened in July 2001 with patients appearing at the hospital on July 7, in Murcia, Spain. More than 800 suspected cases were recorded by the time the last case was treated on July 22; 636–696 of these cases were estimated and 449 confirmed (so, at least 16,000 people were exposed to the bacterium) and 6 died . A case-fatality rate of approximately 1%.[18] |
| 2002 | Barrow-in-Furness, England | 2002 Barrow-in-Furness legionellosis outbreak | Air conditioning | 172 | 7 | 4.1% | In 2002, Barrow-in-Furness in England had an outbreak of Legionnaires' disease. Six women and one man died as a result of the illness; another 172 people also contracted the disease. The cause was found to be a contaminated cooling tower at the town's Forum 28 arts centre.[19] Barrow Borough Council later became the first public body in the UK to be charged with corporate manslaughter but were cleared. They were, however, along with architect Gillian Beckingham, fined for breaches of Health and Safety regulations in a trial that ended in 2006. |
| 2003-2004 | Pas-de-Calais, France | Petrochemical plant | Cooling tower | 86 | 18 | 20.93% | This was the worst outbreak of Legionnaires in French history.[20][21] |
| 2004 | Zaragoza, Spain | Hospital | Cooling tower | 27 | 7 | 26% | Five out of seven of the fatalities were above the age of 50.[20] |
| 2005 | Toronto, Canada | Seven Oaks Home for the Aged | Cooling tower | 127 | 21 | 16.5% | In late September, 2005, 127 residents of a nursing home became ill with Legionella pneumophila. Within a week, twenty-one of the residents had died. Culture results at first were negative. The source of the outbreak was traced to the air-conditioning cooling towers on the nursing home's roof.[22] |
| 2005 | Fredrikstad, Norway | Factory | Air scrubber | 103 | 10 | 9.7% | At least 103 people became ill and ten died from Legionnaires' disease caused by bacteria growing in an air scrubber of a nearby factory.[23] |
| 2007 | Jastrzębie Zdrój, Poland | 2nd District Specialist Hospital, Ophthalmic Ward | Water system | 4 | 3 | 75% | In January 2007 in the 2nd district specialist hospital in Jastrzębie-Zdrój two patients on the ophthalmic ward unexpectedly died. It was noted that they suddenly had a high fever, coughs and hallucinations. First they were transferred to the infectious diseases ward for some hours with a suspicion of pneumonia, later they were transferred to intensive care.
Tests showed that both patients had legionellosis. The disease proved to be the cause of death of one of the patients, the other also had circulatory failure. The bacteria responsible for legionellosis was found in four patients from this hospital.[24] In total the outbreak resulted in three deaths[25] |
| 2008 | New Brunswick, New Jersey, United States | Saint Peter's University Hospital | Drinking water | 6 | 2 | 33.3% | Chlorination in the water system had dropped below effective levels.[26] |
2010s
| Year | City | Venue | Source | Cases | Deaths | Fatality rate | Notes |
|---|---|---|---|---|---|---|---|
| 2010 | Wales | South Wales Valleys | Likely cooling towers | 22 | 2 | 9% | Thought to be cooling towers in local industry.[27] |
| 2011 | Dayton, Ohio, United States | Dayton | Hospital air conditioning | 11 | 5 | 45% | Was the largest outbreak in Ohio since 1994 at the time.[20] |
| 2012 | Québec City, Canada | Lower Québec City | Possibly cooling towers | 180 | 13 | 7.22% | 180 confirmed cases as of September 14, 2012, probably due to contaminated water in industrial cooling towers.[28] |
| 2012 | Calp, Spain | AR Diamante Beach Hotel | Plumbing system | 18 | 3 | 17% | Large hotel with solar water heating system for spa and domestic hot water. A month before the deaths, local government authorities may have known about the problem, but were accused of not alerting the public to avoid disruption of the tourism industry.[29] |
| 2012 | Edinburgh, Scotland | South west of Edinburgh | Possibly cooling towers | 92 | 4 | 3% | 56 confirmed cases, with a further 36 suspected cases, bringing the total number of people affected to 92. Four people are known to have died from the outbreak.[30] |
| 2012 | Chicago, Illinois, United States | JW Marriott Hotel | Decorative Lobby Fountain | 10 | 3 | 30% | 8 confirmed cases with people who stayed at the JW Marriott Chicago during July–August 2012.[31] |
| 2012 | Auckland, New Zealand | Unknown | Water Source and/or Air Conditioning | 11 | 1 | 9% | The number of people affected in a major outbreak of Legionnaires' disease in Auckland, which has claimed one life, has risen to 11.[32] |
| 2012 | Stoke-on-Trent, England | Warehouse, Fenton | Hot tub | 19 | 1 | 5.2% | Infection began in warehouse hot tub. Seventeen of the confirmed cases visited the warehouse a couple of weeks before becoming ill.[33] |
| 2012 | Pittsburgh, Pennsylvania, United States | Veteran's Administration Hospital | unknown | 22 | 6 | 27% | 2012 Pittsburgh legionellosis outbreak[34][35][36] |
| 2014 | Portugal | 2014 Legionella outbreak in Portugal | Cooling tower[37] | 375 | 12 | 3.2% | A widespread outbreak in Vila Franca de Xira district, Portugal.[38] |
| 2015 | Bronx, New York, United States | Co-op City | Co-Op City Cooling Towers | 12 | 0 | 0.0% | 12 people sickened in January 2015. No fatalities reported.[39] |
| 2015 | Bronx, New York, United States | South Bronx | Lincoln Hospital and Concourse Plaza Cooling Towers | 113 | 12 | 10.6% | The 2015 New York Legionnaires' disease outbreak was investigated the New York City Health Department[40][41] Out of 17 buildings with cooling towers, five tested positive to the disease, including cooling towers in the Concourse Plaza Hotel and Lincoln Hospital.[42] The Opera House Hotel in the South Bronx is also considered a source of the outbreak.[43] |
| 2015 | Bronx, New York, United States | Morris Park | Unknown | 15 | 1 | 6.6% | The outbreak is currently being investigated by the New York City Health Department[44][45] "Environmentalists sampled 35 cooling towers in the Morris Park area, and 15 came back with positive results."[46] |
| 2015 | Northland, New Zealand | Pahiatua Fonterra Plant | Unknown | 3 | 0 | Unknown | This outbreak occurred at one of Fonterra's milk plants in Northland, New Zealand, in November 2015. Currently three cases have been reported, though currently no deaths. |
| 2015 | Quincy, Illinois, United States | Veterans home | Unknown | 58 | 13 | 27.7% | The outbreak investigation is ongoing[47][48][49] |
| 2014–2016 | Flint, Genesee County, Michigan, United States | Countywide | McLaren Regional Medical Center | 87 | 12 | 13.8% | Investigation by Frontline also examined cases diagnosed as pneumonia that could have been misdiagnosed and diagnosed as Legionnaires' Disease.[50] McLaren and the Michigan Department of Environmental Quality is being sued for $100 million in regards to the outbreak.[51] See also Flint water crisis, possibly linked to legionnaires disease |
| 2016 | Sydney, Australia | Sydney Town Hall | Suspected cooling tower | at least 4 | 0 | [52] | |
| 2017 | Manhattan, New York, United States | Lenox Hill | TBD | 7 | 1 | 14.3% | [53] |
| 2017 | Las Vegas, Nevada, United States | Rio Hotel and Casino | Water system | 2[53] | 0 | 0 | |
| 2017 | Round Rock, Texas, United States | SpringHill Suites hotel | Swimming pool and hot tub | 6[54][55] | 0 | 0 | |
| 2017 | Anaheim, California, United States | Disneyland | Cooling towers | 22 | 1 | 4.5% | [56] |
| 2017 | Lisbon, Portugal | São Francisco Xavier Hospital | Cooling tower[57] | 56 | 6 | 11% | In November 2017, an outbreak of Legionnaires' disease occurred in São Francisco Xavier Hospital, in Lisbon, Portugal. The outbreak resulted in 56 confirmed cases of Legionnaire's disease, of which 6 died.[58] The investigation traced the source of the infection to a cooling tower in the hospital.[59][60] |
| 2018 | Bloomsbury, London | University College London | Water cooler | 1 | 0 | ||
| 2018 | Washington Heights, New York, United States | The Sugar Hill Project (Building)[61][62] | Cooling towers[63][64][61][62] | 27[65][64] | 1[64] | 3.7% | |
| 2019 | Westminster, London, England | Dolphin Square | Water System | 3 | 0 | 0% | First case confirmed by NHS England 20 March 2019.[66] Samples taken from the flexible shower hose and bathroom sink of the affected resident's flat, showed legionella bacteria present in those specific locations. Third case confirmed by Public Health England 1 July 2019. |
| 2019 | Evergem, Belgium | Ghent/Evergem Port[67] Stora Enso[68] | Cooling Towers[67] | 32[69] | 2[70] | 6.7% | Five samples collected from 17 initially suspected cooling towers at the Port of Ghent near Evergem, tested positive for Legionella pneumophila, 3 with average and 2 in high quantities.[67][71] Genetic testing confirmed 1 of 2 towers with high quantities to have links with the patients.[72] Swedish-Finnish Stora Enso admitted to be responsible.[73] |
| 2019 | Ohio, New Jersey and Michigan, United States | Multiple locations | Not yet determined Flint MI Water Crisis | 32 | 6 | 18.75% | As of June 4, 2019, 32 have fallen sick during the outbreaks across the states of New Jersey and Ohio. Many have fallen sick and died from drinking or being near the contaminated water in Flint, Mi. |
| 2019 | Atlanta, United States | Sheraton downtown | 11 | 0 | Legionnaires’ Disease Outbreak May Have Sickened Dozens in Atlanta Archived 2022-09-21 at the Wayback Machine | ||
| 2019 | Fletcher, North Carolina, United States | North Carolina Mountain State Fair | hot tub display | 141 | 4 |
Four People Have Died From A Legionnaires' Outbreak Linked To A Hot Tub Display At A State Fair Archived 2020-08-03 at the Wayback Machine Legionnaires’ outbreak linked to hot tub display kills third North Carolina fairgoer Archived 2019-12-25 at the Wayback Machine N.C. Officials Trace 124 Legionnaires' Disease Cases To Hot Tub At A Fair Archived 2023-04-14 at the Wayback Machine Investigation of an Outbreak of Legionellosis in Western North Carolina Archived 2022-11-25 at the Wayback Machine |
2020s
| Year | City | Venue | Source | Cases | Deaths | Fatality Rate | Notes |
|---|---|---|---|---|---|---|---|
| 2020 | Vernon Hills, Illinois,
United States |
Brookdale Senior Living | Under investigation | 5 | 1 | 20% | Outbreak of Legionnaires' disease up to five reported cases at Vernon Hills senior living center.[74]
Number Of Legionnaires Cases Rises To Five At Brookdale Vernon Hills Senior Living Facility.[75] |
| 2020 | Vila do Conde, Póvoa do Varzim, Matosinhos, Porto District,
Portugal |
Multiple locations | Under investigation | 88 | 15 | 17% | 88 cases and 15 deaths (11 of these were also infected with SARS-CoV-2). The source of the bacteria is still unknown. The deadliest Legionella outbreak in Portugal, it was declared extinct on January 13, 2021.[76] |
| 2022 | San Miguel de Tucumán, Tucumán Province,
Argentina |
Health clinic | Under investigation | 22 | 6 | 45% | Cluster of pneumonia cases associated with a health clinic. 22 cases and 6 deaths (all with comorbidities). The source of the bacteria is still unknown.[77] |
Governmental controls to prevent outbreaks
Regulations and ordinances
The guidance issued by the UK government's Health and Safety Executive (HSE) now recommends that microbiological monitoring for wet cooling systems, using a dipslide, should be performed weekly. The guidance now also recommends that routine testing for legionella bacteria in wet cooling systems be carried out at least quarterly, and more frequently when a system is being commissioned, or if the bacteria have been identified on a previous occasion.[78] Further non-statutory UK guidance from the Water Regulations Advisory Scheme now exists for pre-heating of water in applications such as solar water heating systems.[79]
The City of Garland, Texas, United States requires yearly testing for legionella bacteria at cooling towers at apartment buildings.[80]
Malta requires twice yearly testing for Legionella bacteria at cooling towers and water fountains. Malta prohibits the installation of new cooling towers and evaporative condensers at health care facilities and schools.[81]
The Texas Department of State Health Services has provided guidelines for hospitals to detect and prevent the spread of nosocomial infection due to legionella.[82] The European Working Group for Legionella Infections (EWGLI)[83] was established in 1986 within the European Union framework to share knowledge and experience about potential sources of Legionella and their control. This group has published guidelines[84] about the actions to be taken to limit the number of colony forming units (i.e., the "aerobic count") of micro-organisms per mL at 30 °C (minimum 48 hours incubation):
| Aerobic count | Legionella | Action required |
|---|---|---|
| 10,000 or less | 1,000 or less | System under control. |
| more than 10,000 up to 100,000 | more than 1,000 up to 10,000 | Review program operation. The count should be confirmed by immediate re-sampling. If a similar count is found again, a review of the control measures and risk assessment should be carried out to identify any remedial actions. |
| more than 100,000 | more than 10,000 | Implement corrective action. The system should immediately be re-sampled. It should then be 'shot dosed' with an appropriate biocide, as a precaution. The risk assessment and control measures should be reviewed to identify remedial actions. |
Almost all natural water sources contain Legionella and their presence should not be taken as an indication of a problem. The tabled figures are for total aerobic plate count, cfu/ml at 30 °C (minimum 48 hours incubation) with colony count determined by the pour plate method according to ISO 6222(21) or spread plate method on yeast extract agar. Legionella isolation can be conducted using the method developed by the US Center for Disease Control using buffered charcoal yeast extract agar with antibiotics.
Copper-Silver ionization is an effective industrial control and prevention process to eradicate Legionella in potable water distribution systems and cooling towers found in health facilities, hotels, nursing homes and most large buildings. In 2003, ionization became the first such hospital disinfection process to have fulfilled a proposed four-step modality evaluation; by then it had been adopted by over 100 hospitals.[85] Additional studies indicate ionization is superior to thermal eradication.[86]
A 2011 study by Lin, Stout and Yu found Copper-Silver ionization to be the only Legionella control technology which has been validated through a 4-step scientific approach.[87]
It was previously believed that transmission of the bacterium was restricted to much shorter distances. A team of French scientists reviewed the details of an epidemic of Legionnaires' disease that took place in Pas-de-Calais in northern France in 2003–2004. There were 86 confirmed cases during the outbreak, of whom 18 died. The source of infection was identified as a cooling tower in a petrochemical plant, and an analysis of those affected in the outbreak revealed that some infected people lived as far as 6–7 km from the plant.[21]
A study of Legionnaires' disease cases in May 2005 in Sarpsborg, Norway concluded that: "The high velocity, large drift, and high humidity in the air scrubber may have contributed to the wide spread of Legionella species, probably for >10 km."[88]
In 2010 a study by the UK Health Protection Agency reported that 20% of cases may be caused by infected windscreen washer systems filled with pure water. The finding came after researchers spotted that professional drivers are five times more likely to contract the disease. No cases of infected systems were found whenever a suitable washer fluid was used.[89]
Temperature affects the survival of Legionella as follows:[90]
- 70 to 80 °C (158 to 176 °F): Disinfection range
- At 66 °C (151 °F): Legionellae die within 2 minutes
- At 60 °C (140 °F): They die within 32 minutes
- At 55 °C (131 °F): They die within 5 to 6 hours
- Above 50 °C (122 °F): They can survive but do not multiply
- 35 to 46 °C (95 to 115 °F): Ideal growth range
- 20 to 50 °C (68 to 122 °F): Growth range
- Below 20 °C (68 °F): They can survive but are dormant
Removing slime, which can carry legionellae when airborne, may be an effective control process.[91]
See also
References
- ↑ Ryan KJ, Ray CG (editors) (2004). Sherris Medical Microbiology (4th ed.). McGraw Hill. ISBN 0-8385-8529-9.
- ↑ Swanson M, Heuner K (2008). Legionella: Molecular Microbiology. Caister Academic Pr. ISBN 978-1-904455-26-4.
- ↑ Altman LK (August 1, 2006). "In Philadelphia 30 Years Ago, an Eruption of Illness and Fear". The New York Times. Archived from the original on June 26, 2022. Retrieved April 17, 2023.
- ↑ "Legionella Outbreak Toolbox". legionnaires.ecdc.europa.eu. Archived from the original on 2020-12-05. Retrieved 2020-07-01.
- ↑ B. D. Colen (1977-01-31). "'Legion Fever' Germ Killed 16 Here in 1965". Washington Post. Archived from the original on 2019-10-09. Retrieved 16 December 2021.
- ↑ "Timeline: legionnaires' disease outbreaks in Britain". The Daily Telegraph. Telegraph Media Group Limited. 2012-06-06. Archived from the original on 2015-10-07. Retrieved 31 July 2015.
- ↑ McDade JE, Brenner DJ, Bozeman FM (April 1979). "Legionnaires' disease bacterium isolated in 1947". Annals of Internal Medicine. 90 (4): 659–61. doi:10.7326/0003-4819-90-4-659. PMID 373548.
- ↑ Fraser DW, Tsai TR, Orenstein W, Parkin WE, Beecham HJ, Sharrar RG, Harris J, Mallison GF, Martin SM, McDade JE, Shepard CC, Brachman PS (December 1977). "Legionnaires' disease: description of an epidemic of pneumonia". New England Journal of Medicine. 297 (22): 1189–97. doi:10.1056/NEJM197712012972201. PMID 335244.
- ↑ Tsai TF, Finn DR, Plikaytis BD, McCauley W, Martin SM, Fraser DW (April 1979). "Legionnaires' disease: clinical features of the epidemic in Philadelphia". Annals of Internal Medicine. 90 (4): 509–17. doi:10.7326/0003-4819-90-4-509. PMID 434627.
- 1 2 3 4 5 6 7 8 9 10 11 Broadbent C (1996). Guidance for the Control of Legionella. National Environmental Health Forum Monographs. ISBN 978-0-642-25247-0.
- ↑ "The Westfriese Flora flower exhibition and fair". Q-net.net.au. Archived from the original on 2009-03-02. Retrieved 2010-09-11.
- ↑ "25 februari 1999: Legionellabesmetting Westfriese Flora, Bovenkarspel" (in Nederlands). Zwaailichten disaster website. 2005. Archived from the original on December 15, 2007. Retrieved December 2, 2011.
- ↑ Greig JE, Carnie JA, Tallis GF, Ryan NJ, Tan AG, Gordon IR, Zwolak B, Leydon JA, Guest CS, Hart WG (June 2004). "An outbreak of Legionnaires' disease at the Melbourne Aquarium, April 2000: investigation and case-control studies". Medical Journal of Australia. 180 (11): 566–72. doi:10.5694/j.1326-5377.2004.tb06093.x. PMID 15174987. S2CID 15441893. Archived from the original on 2011-09-09. Retrieved 2023-04-17.
- ↑ "Legionella pneumophila cases" (PDF). Docs2.health.vic.gov.au. Archived (PDF) from the original on 2016-02-04. Retrieved 2015-08-30.
- ↑ "Health (Legionella) Regulations 2001 S.R. No. 13/2001" (PDF). Legislation.vic.gov.au. Archived (PDF) from the original on 2011-04-01. Retrieved 2017-07-01.
- 1 2 Vizela já enfrentou a legionella em Agosto de 2000 com 11 infectados [Vizela already faced legionella in August 2000, with 11 cases] (in português). Porto Canal. 13 November 2014. Archived from the original on 28 January 2022. Retrieved 5 March 2019.
- 1 2 Correia, AM; Gonçalves, G; Reis, J; Cruz, JM; Castro e Freitas, JA (July 2001). "An outbreak of legionnaires disease in a municipality in northern Portugal". Euro Surveill. 6 (7): 121–4. doi:10.2807/esm.06.07.00228-en. PMID 12631957.
- 1 2 García-Fulgueiras A, Navarro C, Fenoll D, García J, González-Diego P, Jiménez-Buñuales T, Rodriguez M, Lopez R, Pacheco F, Ruiz J, Segovia M, Balandrón B, Pelaz C (August 2003). "Legionnaires' disease outbreak in Murcia, Spain". Emerging Infectious Diseases. 9 (8): 915–21. doi:10.3201/eid0908.030337. PMC 3020623. PMID 12967487.
- ↑ "legionnaires disease, Barrow-in-Furness". Archived from the original on 2002-08-16. Retrieved 2013-08-30.
- 1 2 3 "The 12 Worst Legionnaires Outbreaks in the World". Healthcare Business & Technology. May 11, 2012. Archived from the original on 4 June 2019. Retrieved 3 June 2019.
- 1 2 Nguyen TM, Ilef D, Jarraud S, Rouil L, Campese C, Che D, Haeghebaert S, Ganiayre F, Marcel F, Etienne J, Desenclos JC (January 2006). "A community-wide outbreak of legionnaires disease linked to industrial cooling towers--how far can contaminated aerosols spread?". The Journal of Infectious Diseases. 193 (1): 102–11. doi:10.1086/498575. PMID 16323138.
- ↑ "Toronto legionnaires' outbreak linked to 3 more deaths". CBC News. October 21, 2005. Archived from the original on February 16, 2022. Retrieved April 17, 2023.
- ↑ Simonsen Ø, Wedege E, Kanestrøm A, Bolstad K, Aaberge IS, Ragnhildstveit E, Ringstad J (March 2015). "Characterization of the extent of a large outbreak of Legionnaires' disease by serological assays". BMC Infectious Diseases. 15: 163. doi:10.1186/s12879-015-0903-2. PMC 4383209. PMID 25887275.
- ↑ www.ideo.pl, Ideo Sp. z o.o. -. "Legionellosis case in Jastrzębie-Zdrój will be included in subject literature | News | Science & Scholarship in Poland". scienceinpoland.pap.pl. Archived from the original on 2017-08-02. Retrieved 2017-08-02.
- ↑ "Wyborcza.pl". wyborcza.pl. Archived from the original on 2017-08-02. Retrieved 2017-08-02.
- ↑ "Second patient with Legionnaires' disease dies at New Brunswick hospital". The Star-Ledger. September 24, 2008. Archived from the original on 2011-10-19. Retrieved 2011-10-08.
- ↑ "South Wales legionnaires' disease outbreak declared over". NHS Wales. 12 October 2010. Archived from the original on 21 March 2011. Retrieved 6 June 2012.
- ↑ "DRSP - Direction régionale de santé publique de la Capitale-Nationale" (in français). September 12, 2012. Archived from the original on 2012-10-17. Retrieved 2013-08-30.
- ↑ Govan F (7 February 2012). "Legionnaires' disease that killed three Britons at Spanish hotel was detected a month before action taken". The Daily Telegraph. Archived from the original on 2017-10-16. Retrieved 2017-01-18.
- ↑ "Legionnaires' Disease outbreak: Third death reported". bbc.co.uk. 3 July 2012. Archived from the original on 3 July 2012. Retrieved 3 July 2012.
- ↑ "3 dead in Legionnaires' outbreak tied to downtown hotel". Chicago Tribune. August 27, 2012. Archived from the original on 2012-08-27. Retrieved 2012-08-27.
- ↑ "Legionnaires' cases rise to 11". [The Press]. April 6, 2012. Archived from the original on 2012-06-15. Retrieved 2012-06-04.
- ↑ "Stoke-on-Trent Legionnaires' source 'could be hot tub'". [The Press]. July 31, 2012. Archived from the original on 2012-08-02. Retrieved 2012-08-02.
- ↑ Pittsburgh Veteran's Administration Hospital water contamination investigation ongoing
- ↑ Noah Brode (23 April 2013). "Investigation Reveals Failures of Pittsburgh VA Hospital in Legionnaires' Outbreak". wesa.fm. Archived from the original on 27 March 2019. Retrieved 17 April 2023.
- ↑ "Families of Legionnaires' victims outraged by report on VA outbreak". Pittsburgh Post-Gazette. Archived from the original on 2021-03-24. Retrieved 2023-04-17.
- ↑ "Joint Communication — Preliminary report of Legionnaries' disease 07 to 21 November 2014". Direção-Geral da Saúde. 21 November 2014. Archived from the original on 18 December 2014. Retrieved 5 March 2019.
- ↑ "Extinto o surto de legionella". rr.sapo.pt (in português). November 21, 2014. Archived from the original on November 29, 2014. Retrieved November 23, 2014.
- ↑ "Co-op City towers contaminated with Legionnaires' Disease". New York Daily News. 2015-01-13. Archived from the original on 2015-09-04. Retrieved 2015-08-29.
- ↑ "Legionnaires' Disease Bacteria Found in A/C on Bronx Hospital, Mayor says". DNAinfo New York. Archived from the original on 2015-08-01.
- ↑ David Shortell (2 August 2015). "There have been 65 cases since mid-July". CNN News. Archived from the original on 21 September 2022. Retrieved 17 April 2023.
- ↑ "City confirms 71 cases of Legionnaire's Disease". capitalnewyork.com. Archived from the original on 2016-03-07. Retrieved 2023-04-17.
- ↑ Hu, Winnie; Remnick, Noah (10 August 2015). "Hotel that enlivened the Bronx is now a 'hot spot' for Legionnaire's". The New York Times. Archived from the original on 3 February 2023. Retrieved 17 April 2023.
- ↑ "Health Department Investigating Cluster of Legionnaires' Disease in Morris Park Section of the Bronx" (Press release). City of New York. September 28, 2015. Archived from the original on September 30, 2015. Retrieved September 30, 2015.
- ↑ "Legionnaires' Disease". Department of Health and Mental Hygiene. City of New York. Archived from the original on October 7, 2015. Retrieved October 6, 2015.
- ↑ Campanile C (September 30, 2015). "Latest Bronx Legionnaires' disease outbreak turns fatal". New York Post. Archived from the original on September 30, 2015. Retrieved September 30, 2015.
- ↑ "Illinois is spending $2.3M to fix a Legionnaires disease outbreak in Quincy". Journal Star. Peoria, IL. 2015-09-10. Archived from the original on 2018-07-24. Retrieved 2017-07-01.
- ↑ "Death toll stands at 13 after Quincy Legionnaires' outbreak". Abc7chicago.com. 2015-09-17. Archived from the original on 2016-07-07. Retrieved 2017-07-01.
- ↑ "Fourth case of Legionnaires' disease confirmed at Quincy veterans home in one week". WQAD.com. 2018-02-21. Archived from the original on 2018-07-24. Retrieved 2018-07-24.
- ↑ https://www.pbs.org/wgbh/frontline/article/flint-water-crisis-legionnaires-disease-deaths Archived 2023-04-17 at the Wayback Machine (April 25, 2019). Retrieved October 28, 2019.
- ↑ John Wisely & Jennifer Dixon, Fieger files $100-million suit over Flint Legionnaires' disease cases Archived 2023-04-06 at the Wayback Machine, Detroit Free Press (February 2, 2016).
- ↑ "Town Hall area cooling tower suspected after four men contract Legionnaires disease". The Sydney Morning Herald. 2016-03-09. Archived from the original on 2016-03-10. Retrieved 2016-03-10.
- 1 2 Nir SM (2017-06-16). "Legionnaires' Outbreak on Upper East Side Kills One and Sickens Six". The New York Times. ISSN 0362-4331. Archived from the original on 2017-06-17. Retrieved 2017-06-17.
- ↑ Austin, CBS. "Sixth case of Legionnaires' disease confirmed at Round Rock hotel". KEYE. Archived from the original on 2017-10-11. Retrieved 2017-10-10.
- ↑ Osborn C (2017-10-10). "Sixth case of Legionnaires' disease confirmed from Round Rock hotel". Austin American-Statesman. Archived from the original on 2017-10-11. Retrieved 2017-10-10.
- ↑ Perez M (November 11, 2017). "Disneyland shuts down two cooling towers after Legionnaires' disease outbreak". Newsweek. Archived from the original on November 12, 2017. Retrieved November 11, 2017.
- ↑ "Surto de legionella com origem pelo menos numa das torres de arrefecimento do São Francisco Xavier" [Legionella outbreak with origin in at least one of the cooling towers of São Francisco Xavier]. Jornal de Negócios (in português). November 16, 2017. Archived from the original on November 16, 2017. Retrieved November 24, 2017.
- ↑ "Comunicado — 03/12/2017" [Communiqué — 3 December 2017]. Direção-Geral da Saúde (in português). 3 December 2017. Archived from the original on 4 December 2017. Retrieved 5 March 2019.
- ↑ Campos, Alexandra (17 November 2017). "Torre de arrefecimento do S. Francisco Xavier tinha estirpe fatal de Legionella" [Cooling tower in S. Francisco Xavier Hospital had the fatal strain of Legionella] (in português). Público. Archived from the original on 6 March 2019. Retrieved 5 March 2019.
- ↑ David Cardoso, Margarida (29 November 2017). "Torre de refrigeração na origem do surto tinha manutenção deficiente, diz DGS" [Cooling tower at the origin of the outbreak had poor maintenance, says Directorate General for Health] (in português). Público. Archived from the original on 6 March 2019. Retrieved 5 March 2019.
- 1 2 "pr065-18". www1.nyc.gov. Archived from the original on 2018-09-06. Retrieved 2018-09-06.
- 1 2 "NYC Health Officials ID Source Of Legionnaires' Outbreak In Upper Manhattan". 2018-08-15. Archived from the original on 2018-09-06. Retrieved 2018-09-06.
- ↑ Levine, Alexandra S. (17 July 2018). "New York Today: A Legionnaires' Disease Outbreak". The New York Times. Archived from the original on 2018-07-18. Retrieved 2018-07-18.
- 1 2 3 "NYC Legionnaires cluster up to 18 cases, 1 death reported". ABC7 New York. 2018-07-17. Archived from the original on 2018-07-17. Retrieved 2018-07-18.
- ↑ "Notice to Residents of Lower Washington Heights" (PDF). NYC Department of Heath. NYC Department of Health. 24 June 2018. Archived (PDF) from the original on 18 July 2018. Retrieved 24 July 2018.
- ↑ "Health officials probe case of deadly Legionnaires' Disease at one of London's most famous apartment blocks". Evening Standard. 21 March 2019. Archived from the original on 30 March 2019. Retrieved 18 June 2019.
- 1 2 3 "5 positieve stalen met legionella in Evergem". Het Nieuwsblad (in Nederlands). Archived from the original on 2019-05-20. Retrieved 2019-05-20.
- ↑ "karton- en papierfabrikant Stora Enso". Archived from the original on 2019-06-14. Retrieved 2023-04-17.
- ↑ lla, SVG. "Overeenkomst gevonden tussen vijf legionellapatiënten en koeltoren, mogelijk raakten nog meer mensen besmet". Het Nieuwsblad Mobile (in Nederlands). Archived from the original on 2019-05-29. Retrieved 2019-05-29.
- ↑ Maes, Thierry Goeman en Cédric. "50-jarige man eerste dodelijk slachtoffer legionella-uitbraak: "Op het laatste had hij 2 procent longcapaciteit"". Het Nieuwsblad Mobile (in Nederlands). Archived from the original on 2019-05-14. Retrieved 2019-05-14.
- ↑ "Legionella gevonden in stalen Gentse haven". Archived from the original on 2023-07-01. Retrieved 2023-04-17.
- ↑ lla, SVG. "Overeenkomst gevonden tussen vijf legionellapatiënten en koeltoren, mogelijk raakten nog meer mensen besmet". Het Nieuwsblad Mobile (in Nederlands). Archived from the original on 2019-05-29. Retrieved 2019-05-29.
- ↑ tg. "Papierfabrikant veroorzaakte legionella in Gents havengebied". Het Nieuwsblad (in Nederlands). Archived from the original on 2019-06-08. Retrieved 2019-06-14.
- ↑ Norman, James T. "Outbreak of Legionnaires' disease up to five reported cases at Vernon Hills senior living center". Chicago Tribune. Archived from the original on 2020-07-06. Retrieved 2020-07-06.
- ↑ "Number Of Legionnaires Cases Rises To Five At Brookdale Vernon Hills Senior Living Facility". 2020-02-20. Archived from the original on 2020-03-04. Retrieved 2020-07-06.
- ↑ "Surto de Legionnella no Grande Porto dado como extinto com 88 casos e 15 mortos". Observador. 2021-01-13. Archived from the original on 2022-05-25.
- ↑ "Legionella identified as cause of cluster of pneumonia cases in Tucuman, Argentina". PAHO. 2022-09-05. Archived from the original on 2023-01-16.
- ↑ Archived 2012-10-20 at the Wayback Machine
- ↑ Makin T (November 2014). "Preheated Domestic Hot Water: Storage of Preheated Domestic Hot Water and Possible Growth of Legionella Bacteria" (PDF). The Water Regulations Advisory Scheme. Archived from the original on 2017-01-08. Retrieved 2023-04-17.
- ↑ "The Dallas Morning News, Garland tough on bacteria". Dallasnews.com. 2007-02-01. Archived from the original on 2010-04-24. Retrieved 2010-09-11.
- ↑ "299601 Legionella" (PDF). Archived (PDF) from the original on 2011-06-06. Retrieved 2010-09-11.
- ↑ Report of the Texas Legionnaires' Disease Task Force, Texas Department of State Health Services
- ↑ "European Working Group for Legionella Infections". Ewgli.org. Archived from the original on 2012-12-25. Retrieved 2010-09-11.
- ↑ "European Guidelines for Control and Prevention of Travel Associated Legionnaires' Disease". Archived from the original on 2011-07-06. Retrieved 2017-07-01.
- ↑ Stout JE, Yu VL (August 2003). "Hospital-acquired Legionnaires' disease: new developments". Current Opinion in Infectious Diseases. 16 (4): 337–41. doi:10.1097/00001432-200308000-00005. PMID 12861086. S2CID 37897523.
- ↑ Lin YE, Stout JE, Yu VL (2001). "Control of Legionella". In Block SS (ed.). Disinfection, Sterilization, and Preservation. Lippincott Williams & Wilkins. pp. 505–12. ISBN 978-0-683-30740-5. Archived from the original on 2023-07-01. Retrieved 2023-04-17.
- ↑ Lin YE, Stout JE, Yu VL (February 2011). "Controlling Legionella in hospital drinking water: an evidence-based review of disinfection methods". Infection Control and Hospital Epidemiology. 32 (2): 166–73. doi:10.1086/657934. PMID 21460472. S2CID 8790329.
- ↑ Nygård K, Werner-Johansen Ø, Rønsen S, Caugant DA, Simonsen Ø, Kanestrøm A, Ask E, Ringstad J, Ødegård R, Jensen T, Krogh T, Høiby EA, Ragnhildstveit E, Aaberge IS, Aavitsland P (January 2008). "An outbreak of legionnaires disease caused by long-distance spread from an industrial air scrubber in Sarpsborg, Norway". Clinical Infectious Diseases. 46 (1): 61–9. doi:10.1086/524016. PMID 18171215.
- ↑ Wilkinson E (2010-06-13). "Windscreen water infection risk". BBC News. Archived from the original on 2023-07-01. Retrieved 2010-09-11.
- ↑ "Legionella: What is Legionnaires' Disease?". Reliance Worldwide. Archived from the original on October 9, 2007.
- ↑ Potera C (December 1998). "Studying slime". Environmental Health Perspectives. 106 (12): A604-6. doi:10.1289/ehp.98106a604. PMC 1533243. PMID 9831548.
External links
- List of Legionnaires' disease outbreaks at Curlie
- van Amerongen GA, Lee JV, Suter J (April 22, 2013). "Legionella and solar water heaters" (PDF). Archived (PDF) from the original on March 19, 2023. Retrieved April 17, 2023.